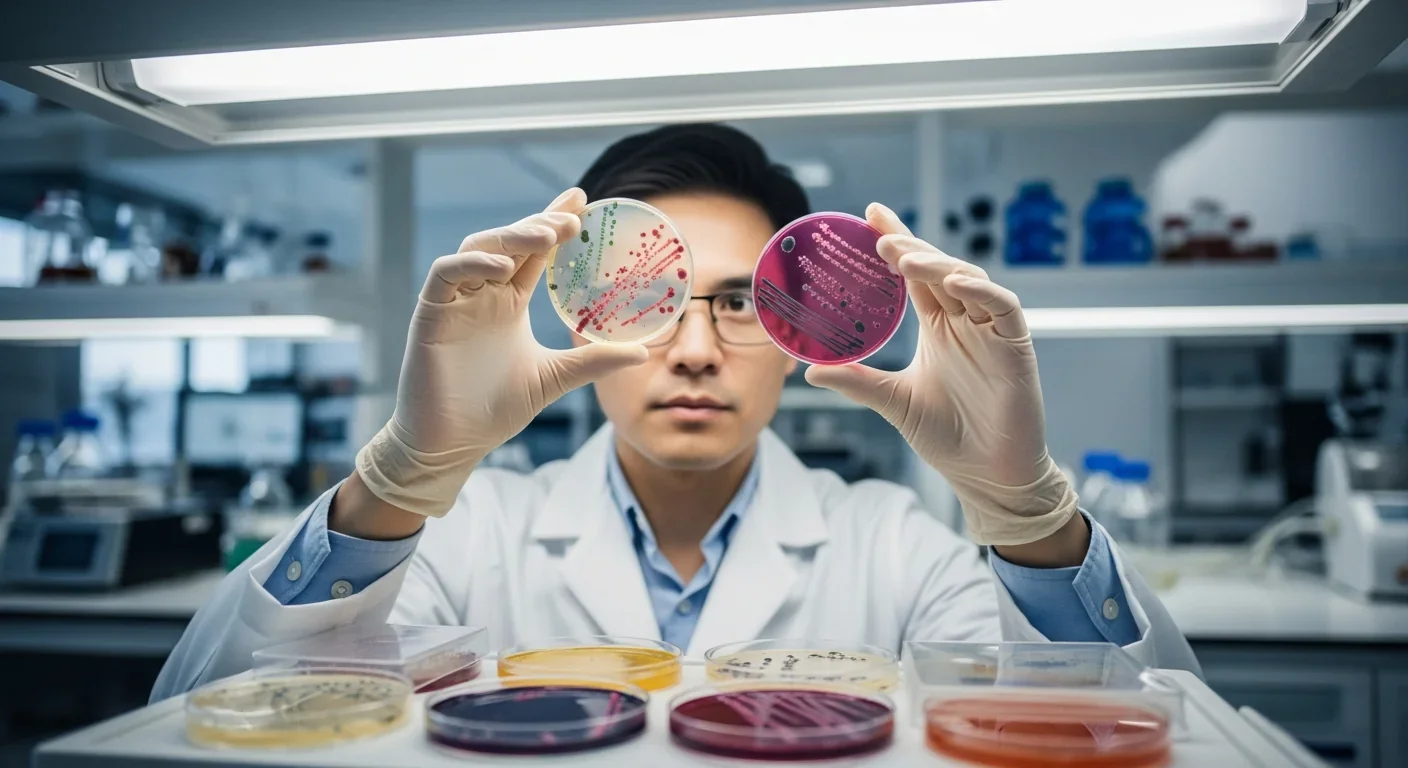
Scientist examining bacterial cultures in petri dishes for microbiome research

Illusory Superiority: Why You Think You're Above Average

TL;DR: Human culture is literally rewriting our genetic code through gene-culture coevolution. From lactose tolerance to digital brain rewiring, cultural practices drive rapid biological evolution within thousands of years.
Imagine discovering that every cultural choice you make - from drinking milk to using smartphones - is actively rewriting humanity's genetic code. This isn't science fiction. It's happening right now, in your body, as multiple research teams worldwide confirm that human culture functions as a powerful evolutionary force, fundamentally altering our biology within just a few thousand years rather than the millions traditionally assumed for genetic change.

Scientists have uncovered something remarkable about our species: we're evolving faster than ever before, and culture is the accelerator. The dual inheritance theory, developed by researchers studying gene-culture coevolution, reveals that humans inherit two distinct but intertwined streams of information - genetic and cultural - that continuously reshape each other in a dynamic feedback loop.
This breakthrough challenges everything we thought we knew about evolution. Where Darwin's original framework required countless generations for meaningful change, modern humans demonstrate rapid biological adaptations within mere millennia. The extended phenotype theory, pioneered by Richard Dawkins, shows that our genes don't just build our bodies - they construct entire environments, technologies, and cultural systems that then reshape our genetic evolution in return.
Consider the profound implications: your ancestors' decision to farm dairy cattle directly altered your genetic code. The cultural practice of dairy farming created selective pressure for lactase persistence, enabling adults to digest milk - a trait that evolved independently in multiple populations within just 10,000 years. In Scandinavia alone, selection coefficients for this trait ranged from 0.09 to 0.19, representing some of the strongest selective pressures ever documented in human evolution.
Human evolution isn't just happening - it's accelerating. Cultural practices can now drive genetic changes in just a few thousand years, fundamentally challenging our understanding of evolution's timeline.
The story of culture-driven evolution begins with our earliest ancestors who first controlled fire approximately 1.5 million years ago. This single cultural innovation triggered a cascade of biological changes that fundamentally altered our species. Cooking food reduced the energy needed for digestion, allowing our digestive systems to shrink while our brains expanded. Our jaws became smaller, our teeth reduced in size, and our intestines shortened - all because we learned to process food with heat.
The agricultural revolution 12,000 years ago marked another pivotal moment in this coevolutionary dance. As humans transitioned from hunting and gathering to farming, our bodies adapted to new diets rich in starches. Populations with agricultural histories developed increased production of amylase, the enzyme that breaks down starches, with some groups producing up to six times more salivary amylase than their hunter-gatherer counterparts.
But perhaps no example illustrates culture's biological impact more clearly than the evolution of lactose tolerance. When humans began domesticating cattle and goats around 10,000 years ago in the Middle East and Africa, only infants could digest milk. Yet within a few thousand years - a blink in evolutionary time - multiple populations independently evolved lactase persistence, the ability to produce lactase throughout adulthood. Today, this trait appears in over 90% of Northern Europeans, demonstrating evolution at breakneck speed.

These transformations weren't gradual. Archaeological evidence reveals that European populations went from nearly zero lactose tolerance to widespread prevalence in just 3,000 years. The cultural practice of dairying created such intense selective pressure that individuals with lactase persistence had significantly more surviving offspring, rapidly spreading the trait through populations.
"Our genes and our culture are in a constant dialogue, a feedback loop where each influences the other's evolution."
- Dual-Inheritance Theory researchers
Today, we're witnessing the most rapid cultural-biological transformation in human history. Digital technology, social media, and artificial intelligence aren't just changing how we live - they're rewiring our brains at the cellular level. A comprehensive review of neuroscience research reveals that constant interaction with digital devices alters neural pathways, attention spans, and even the physical structure of our brains.
Children born into the digital age show markedly different brain development patterns compared to previous generations. Their neural networks optimize for rapid information processing, multitasking, and visual-spatial skills while potentially sacrificing deep focus and sustained attention. These aren't temporary changes - they represent fundamental rewiring of human cognitive architecture that may persist across generations through epigenetic mechanisms.
The implications extend beyond individual brains. Research on cultural brain evolution suggests that societies with complex technologies develop distinct cognitive profiles. Urban populations exposed to constant sensory stimulation evolve different stress responses and attention mechanisms compared to rural communities. Our smartphones, social networks, and digital environments function as extended phenotypes - external structures created by our genes that subsequently modify our genetic evolution.
Consider how rapidly these changes occur. The iPhone launched just 17 years ago, yet already we observe measurable changes in thumb anatomy among heavy smartphone users, altered sleep-wake cycles tied to screen exposure, and modified social bonding mechanisms adapted to digital communication. If cultural practices can alter our genetics within thousands of years, what will decades of intensive digital immersion produce?
The digital devices in your pocket aren't just tools - they're evolutionary forces actively reshaping human biology at unprecedented speed.
Richard Dawkins' revolutionary concept of the extended phenotype transforms how we understand human evolution. Just as beaver dams and spider webs represent genetic information expressed in the environment, human cities, technologies, and social institutions function as external manifestations of our genes. But unlike other species, our extended phenotypes create feedback loops that accelerate our own evolution.
Niche construction theory reveals how humans don't just adapt to environments - we create them, and these constructed niches become the primary drivers of our evolution. Cities, for instance, represent massive extended phenotypes that expose millions to novel selective pressures: air pollution that favors certain respiratory adaptations, artificial lighting that alters circadian rhythms, and dense social networks that select for specific cognitive and immune system traits.

Our built environments now exert stronger evolutionary pressure than natural environments. Modern humans spend 90% of their time indoors, breathing filtered air, experiencing controlled temperatures, and interacting with engineered materials. These conditions select for different traits than those favored by natural selection. Research on urban evolution documents rapid changes in everything from our microbiomes to our stress responses, all driven by the environments we've created.
Language itself represents perhaps the most powerful extended phenotype. As cultural evolution researcher Kevin Laland argues, human language doesn't just transmit information - it structures how our brains develop, creating cognitive architectures optimized for linguistic processing. Children raised in different linguistic environments literally develop different neural structures, demonstrating how cultural tools become biological realities.
Across the globe, diverse cultural practices drive unique evolutionary trajectories in different populations. The Bajau people of Southeast Asia evolved enlarged spleens for deep-sea diving, Tibetan populations developed unique hemoglobin adaptations for high-altitude living, and East African pastoral groups independently evolved lactase persistence through different genetic mutations than Europeans.
These adaptations emerged not from environmental pressures alone but from cultural practices that placed humans in these challenging environments. The Bajau's thousand-year tradition of free-diving for food created selective pressure for enhanced oxygen storage. Tibetan cultural practices that encouraged settlement at extreme altitudes drove rapid evolution of blood chemistry. Each culture, through its unique practices and traditions, sculpts its own biological destiny.
Modern globalization adds another layer to this evolutionary story. As cultures mix and blend, we're witnessing unprecedented genetic exchange and cultural hybridization. International cities become evolutionary hotspots where diverse genetic backgrounds meet novel cultural practices, potentially accelerating human evolution beyond anything seen before. Studies of cosmopolitan populations reveal rapid changes in everything from disease resistance to cognitive patterns, driven by the cultural melting pot of urban life.
Yet this same globalization threatens evolutionary diversity. As traditional cultures disappear, we lose not just cultural knowledge but unique evolutionary experiments. Indigenous populations that developed specific adaptations over millennia - from the ability to process toxic plants to resistance against regional diseases - represent irreplaceable genetic and cultural heritage. The homogenization of human culture through globalization may paradoxically reduce our species' adaptive potential just when we need it most.
"Each culture, through its unique practices and traditions, sculpts its own biological destiny."
- Evolutionary anthropologists studying global populations
Perhaps nowhere is the culture-biology connection more intimate than in our microbiomes. The trillions of bacteria living in and on our bodies aren't passive passengers - they're active participants in our evolution, passed from generation to generation like genes themselves. Cultural practices from diet to hygiene fundamentally shape these microbial communities, which in turn influence everything from our immune systems to our brain chemistry.
Traditional fermented foods - from Korean kimchi to Ethiopian injera - don't just provide nutrition. They introduce specific bacterial strains that have coevolved with human populations for millennia. When cultural practices change, such as the Western shift toward processed foods and antibiotics, our microbiomes transform within a single generation. These changes correlate with rising rates of autoimmune disorders, allergies, and mental health conditions, suggesting that rapid cultural shifts can disrupt millions of years of coevolution.
Recent research reveals that microbiome composition influences gene expression through epigenetic mechanisms, meaning that culturally-driven dietary changes can alter how our genes function without changing the DNA sequence itself. A Japanese population's unique ability to digest seaweed comes not from human genes but from marine bacteria acquired through centuries of consuming raw seaweed, which transferred genes to gut bacteria. This represents evolution by cultural practice occurring not in human DNA but in our bacterial partners.
The implications for modern medicine are profound. As we recognize the microbiome's role in human evolution, we must reconsider how antibiotics, cesarean births, and formula feeding - all recent cultural innovations - might be inadvertently directing human evolution. Each generation inherits not just genes and culture but a microbial legacy shaped by cultural practices, creating a three-way evolutionary dance between genes, culture, and microbes.
Artificial intelligence and biotechnology aren't just tools - they're becoming evolutionary forces that may surpass natural selection in shaping human biology. CRISPR gene editing allows direct manipulation of our genetic code, while brain-computer interfaces promise to merge human cognition with artificial intelligence. These technologies represent a fundamental shift: humans taking conscious control of their own evolution.
The quantified self movement, where individuals track everything from heart rate to glucose levels, creates new selective pressures. People optimize their behaviors based on data, potentially favoring genetic variants that respond well to such optimization. Dating apps that use genetic testing to match partners could alter the genetic structure of future populations. Social media algorithms that determine what information we see may influence which cultural practices spread and thus which evolutionary pressures dominate.
Virtual and augmented reality technologies create entirely artificial environments where humans increasingly live, work, and socialize. As we spend more time in virtual worlds, our brains and bodies adapt to these digital realms. Studies already show that heavy VR users develop enhanced spatial processing abilities but may lose certain real-world navigation skills. If virtual environments become primary human habitats, they'll drive evolution in unprecedented directions.
Consider the implications of life extension technologies. If humans regularly live to 150 or 200 years, the evolutionary landscape transforms completely. Longer lifespans mean fewer generations over time, potentially slowing genetic evolution while accelerating cultural evolution. Reproductive patterns would shift dramatically, possibly favoring genes that maintain fertility longer or support extreme longevity. The cultural practice of life extension itself becomes an evolutionary force, reshaping the human genome in ways we're only beginning to imagine.
We're entering an era where technology doesn't just serve humanity - it actively rewrites our biological code, potentially at speeds that outpace natural evolution by orders of magnitude.
As we recognize culture's power to reshape biology, we face unprecedented ethical questions. If cultural practices drive genetic evolution, who decides which practices to promote? Should we actively design cultures to produce desired biological outcomes? The ability to consciously direct human evolution through cultural engineering raises profound questions about human freedom, diversity, and identity.
Some argue we have a responsibility to optimize human evolution, using our understanding of gene-culture coevolution to eliminate disease, enhance cognition, and extend healthy lifespan. Others warn that such interventions could reduce genetic diversity, create new forms of inequality, or produce unintended consequences we can't predict. The history of eugenics reminds us how easily scientific knowledge about human evolution can be misused.

The challenge becomes more complex when we consider that we're already directing evolution unconsciously. Every policy decision, from education systems to urban planning, creates selective pressures that shape human biology. The question isn't whether to influence human evolution - we're already doing it - but how to do so ethically and wisely.
International cooperation becomes essential as we grapple with these questions. Evolution doesn't respect national borders, and cultural practices in one region can affect the entire human gene pool. We need global frameworks for discussing and deciding how to handle technologies and practices that could reshape our species. The extended phenotype of human civilization itself requires collective management.
Understanding gene-culture coevolution transforms how we should approach the future. Rather than viewing ourselves as fixed biological entities navigating a changing world, we must recognize ourselves as dynamically evolving beings whose biology and culture continuously reshape each other. This perspective demands new approaches to education, medicine, and social policy.
Educational systems should teach children about their evolutionary nature, helping them understand how their choices and practices influence not just their own lives but potentially the human genome. Medical practitioners need to consider evolutionary perspectives when treating diseases, recognizing that many modern ailments result from mismatches between our evolved biology and current cultural practices. The rapid evolution of antibiotic resistance demonstrates how medical practices themselves drive evolution in real-time.
Individuals can make informed choices about their own evolutionary impact. Understanding that dietary choices, exercise patterns, and technology use potentially influence genetic expression through epigenetic mechanisms empowers people to actively participate in their own evolution. Communities can consciously design cultural practices that promote beneficial adaptations while preserving evolutionary diversity.
We must also develop resilience for rapid evolutionary change. As cultural evolution accelerates through technology, biological evolution struggles to keep pace, creating potential mismatches that manifest as physical and mental health problems. Building cultures that support human wellbeing while embracing beneficial change becomes crucial for navigating our coevolutionary future.
"Understanding gene-culture coevolution empowers people to actively participate in their own evolution through conscious choices about diet, technology use, and cultural practices."
- Contemporary evolutionary biologists
The recognition that culture rewires biology revolutionizes our understanding of what it means to be human. We're not separate from nature, adapting to external environments - we're active creators of our own evolution, building cultural and technological niches that reshape our genetic destiny. Every cultural innovation, from ancient cooking fires to modern smartphones, leaves its mark on the human genome.
This knowledge carries both promise and responsibility. We have the power to consciously influence human evolution through cultural design, potentially eliminating genetic diseases, enhancing human capabilities, and adapting our species for future challenges like climate change or space colonization. Yet this same power could inadvertently reduce genetic diversity, create new vulnerabilities, or lock humanity into evolutionary dead ends.
The feedback loop between genes and culture appears to be accelerating. Where agricultural practices took millennia to alter our genetics, digital technologies might produce measurable changes within decades. As artificial intelligence, biotechnology, and virtual reality mature, they'll create selective pressures unlike anything in human history. The next century could see more evolutionary change than the previous ten thousand years.
Understanding gene-culture coevolution also reframes social and political debates. Discussions about technology adoption, educational practices, dietary guidelines, and urban planning take on new significance when we recognize their potential evolutionary impact. What seems like a simple policy choice today might shape the human genome for generations.
As we stand at this evolutionary crossroads, the science of gene-culture coevolution offers both a warning and an invitation. The warning: our cultural choices have biological consequences that ripple through generations. The invitation: to consciously participate in our own evolution, using wisdom gained from understanding how culture and biology intertwine. The human story is still being written - not just in our cultures and technologies, but in our very DNA. The question now is what kind of story we choose to write.

Saturn's moon Titan may harbour liquid water beneath its frozen crust, kept from freezing by ammonia acting as a natural antifreeze. New Cassini data suggests the interior could be slush with warm water pockets rather than a global ocean, and NASA's Dragonfly mission launching in 2028 aims to investigate whether this exotic environment could support life.

The cerebellum, long dismissed as merely a motor coordinator, forms dense circuits with the prefrontal cortex that shape cognition and emotion. Disruption of these pathways is now linked to schizophrenia, autism, and ADHD, opening new frontiers in diagnosis and non-invasive brain stimulation therapies.

Research shows the sharing economy often increases total resource consumption through the Jevons paradox and rebound effects. Ride-sharing adds billions of vehicle miles, co-working spaces use more energy per worker, and diffused responsibility erodes conservation behavior. Breaking the paradox requires congestion pricing, accountability design, and matching sharing models to appropriate resource types.

Illusory superiority causes most people to rate themselves above average in driving, intelligence, and ethics. This bias is rooted in metacognitive blind spots, shaped by culture, and carries real costs in healthcare, finance, and leadership. Structured feedback and institutional safeguards can help, but require ongoing effort.

Eastern skunk cabbage generates its own body heat through the alternative oxidase pathway, maintaining temperatures up to 35°C above freezing air and melting surrounding snow. This thermogenic ability, shared by roughly 90 plant species worldwide, reveals a level of metabolic sophistication that challenges assumptions about plant passivity.

America has 28 vacant homes for every homeless person, yet homelessness hit record highs in 2024. Speculative investment, geographic mismatches, and political barriers explain the paradox, while Finland and Vienna show that Housing First and social housing models can work when the political will exists.

Wafer-on-wafer bonding fuses logic and memory silicon at the atomic level, delivering up to 100x interconnect density over traditional packaging. TSMC, Intel, and Samsung are racing to commercialize the technology as AI chips hit the memory bandwidth wall.